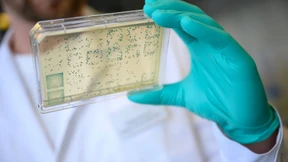
Gemeinsam gegen die Pandemie

WHO: „Europa liegt im Auge des Covid-19-Sturms“
Erstmals seit gut einer Woche steigen die Zahlen der bestätigten Neuinfektionen in Deutschland wieder. Das Europa-Büro der WHO hält die kommenden Wochen für ausschlaggebend im Kampf gegen das Coronavirus.